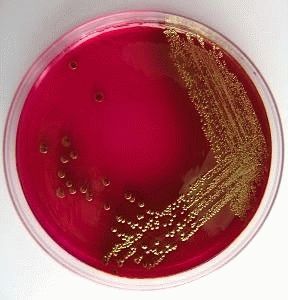

Жжение, дискомфорт, рези при мочеиспускании у женщин — симптомы дизурии. Считается, что появление резей при мочеиспускании свидетельствует об инфекции мочевыводящих путей, но это не совсем правильно, так как этот симптом имеет много причин. Эмпирическое назначение антибиотиков без проведения обследования не всегда обосновано, дизурические расстройства сопровождают, помимо воспаления, целый ряд заболеваний.
Все возможные причины рези при мочеиспускании у женщин
Кроме воспалительного генеза, рези при мочеиспускании встречаются при следующих состояниях:
- механическом раздражении мочеиспускательного канала;
- кольпитах;
- новообразованиях;
- пороках развития мочеполовых путей;
- нейрогенной патологии;
- травмах;
- нарушениях гормонального фона;
- интерстициальном цистите.
Определенные жалобы при мочевыделении отмечены у пациенток, страдающих некоторыми психическими расстройствами.
К инфекционно-воспалительным заболеваниям, при которых рези при мочеиспускании — ведущий симптом — относят:
- цистит;
- уретрит;
- цервицит;
- вульвовагинит.
При пиелонефрите у некоторых женщин также присутствуют симптомы дизурии.
Другие причины:
- Нарушения гормонального фона: гипоэстрогения, эндометриоз.
- Аномалии развития: непроходимость шейки мочевого пузыря, стриктуры и дивертикулы уретры.
- Опухолевые процессы: рак мочеиспускательного канала, мочевого пузыря, влагалища/вульвы.
- Травматицация: ятрогенные повреждения после медицинских вмешательств, цистит медового месяца, длительная катетеризация.
- Прочие условия: прием некоторых препаратов, провоцирующих повышенное солеобразование, аутоиммунные заболевания, спондилоарторопатии, повышенная чувствительность к средствам гигиены, прокладкам, тампонам, использование в качестве контрацептивов агрессивных спермицидных средств, неправильная гигиена.
- Психогенные расстройства: депрессии, длительный стресс, психологические особенности личности с тенденцией к тревожности, истерия.
Обратите внимание
Согласно статистике, на долю обращений по поводу резей при мочеиспускании приходится от 5 до 15 случаев от всех посещений. Возраст женщин с данной проблемой — от 25-55 лет, сексуальная активность относится к провоцирующим дизурические расстройства факторам.
Врачи отмечают, что рези при мочеиспускании у женщин могут быть вызваны различными факторами. Наиболее распространенной причиной является инфекция мочевыводящих путей, которая может проявляться не только болевыми ощущениями, но и частыми позывами к мочеиспусканию. Также рези могут возникать из-за воспалительных процессов в мочевом пузыре или уретре, таких как цистит.
Другими возможными причинами являются камни в мочевом пузыре или почках, а также аллергические реакции на средства личной гигиены. Важно отметить, что рези могут быть симптомом более серьезных заболеваний, таких как половые инфекции или даже онкологические процессы.
Для диагностики и лечения врачи рекомендуют обратиться к специалисту, который проведет необходимые анализы и назначит адекватное лечение. Это может включать антибиотики, противовоспалительные препараты и изменение образа жизни. Врач также подчеркивает важность профилактики, включая соблюдение гигиенических норм и регулярные осмотры.

Наиболее распространенные причины дизурии у женщин
Инфекционно- воспалительные процессы
Инфекция является наиболее частой причиной дизурии, поражаться может любой отдел урогенитального тракта. Анатомические особенности строения женских половых органов, особенности структуры мочевых путей, более слабая местная защита (у мужчин в секрете простаты содержится антибактериальное вещество, препятствующее размножению бактерий) приводят к инфицированию и развитию воспалительного процесса.
Обратите внимание
Согласно проводимым исследованиям, около 2/3 инфекций мочевыводящих путей с резями при мочеиспускании провоцируется Кишечной палочкой, в 15% случаев — диагностируется Эпидермальный стафилококк, в 10% — протей, в 5% — золотистый стафилококк, и по 3 % приходится на Клебсиеллу и Энтерококк.
При аномалиях развития урогенитального тракта чаще высеваются Протей, Клебсиелла и Энтеробактер.
Заражение происходит чаще восходящим путем, но возможен и гематогенный путь распространения инфекции.
Причиной специфического воспаления мочеиспускательного канала в большинстве случаев являются следующие патогены:
- гонококки Нейссера;
- хламидии;
- уреаплазма уреалитикум;
- микоплазма гениталиум;
- трихомонада вагиналис;
- вирус простого герпеса.
Редко к резям при мочеиспускании у женщин приводит аденовирус, вирус паротита, возбудитель шистостомоза.
У женщин в постменопаузе резкое снижение уровня эндогенных эстрогенов приводит к дисфункции нижних мочевых путей. Помимо резей при мочеиспускании, женщину беспокоит следующее:
- атрофия и сухость слизистой оболочки влагалища;
- воспалительный процесс;
- зуд и жжение,
- усиленные выделения;
- ломкость сосудов;
- приливы;
- частое мочеиспускание.
Рези при мочеиспускании у женщин могут быть частью клинической картины почечных камней, новообразований мочевого пузыря и уретры.
Спондилоартропатии (например, синдром Бехчета, Рейтера) могут вызвать воспаление мочевыводящих путей, что приводит к дизурическим расстройствам.
Физические занятия, например, верховая езда или езда на велосипеде иногда провоцируют дискомфорт при выделении мочи.
Резь при мочеиспускании у женщин — это распространённая проблема, о которой часто говорят в медицинских кругах и на форумах. Многие женщины описывают это состояние как острое, жгучее ощущение, которое может сопровождаться частыми позывами к мочеиспусканию. Основные причины рези могут включать инфекции мочевыводящих путей, воспалительные процессы, такие как цистит, или даже камни в почках.
Лечение зависит от причины дискомфорта. Врач может назначить антибиотики для борьбы с инфекцией или противовоспалительные препараты для облегчения симптомов. Также важно пить достаточно жидкости и избегать раздражающих продуктов, таких как кофе и алкоголь. Если резь не проходит, необходимо обратиться к специалисту для более детального обследования и исключения серьёзных заболеваний. Забота о здоровье и своевременное обращение к врачу помогут избежать осложнений и восстановить комфорт.

Диагностические мероприятия
Стандартно, диагностика патологии начинается с беседы с пациенткой. Обращают внимание на следующие факторы:
- время появления;
- частота;
- степень тяжести;
- локализация дизурии.
У женщин болевой синдром может развиваться на фоне раздражения воспаленного влагалища и его преддверия мочой.
Рези вначале акта мочеиспускания свидетельствуют о воспалении уретры, надлобковая боль после завершения мочеиспускания типична для бактериального цистита.
Длительность резей при мочеиспускании и постепенное начало позволяет предположить хламидийную инфекцию, для бактериального воспаления характерно внезапное начало и иногда появление крови в моче (гематурии).
Не меньшую значимость имеют другие урогенитальные симптомы. Рези при мочеиспускании могут сопровождаться ослаблением напора мочи, затрудненностью в начале акта мочевыделения, чувством неполного опорожнения мочевого пузыря.
Частое мочеиспускание малыми порциями может быть признаком уменьшения емкости мочевого пузыря или воспалением. Другие причины включают патологии уретры и центральные и периферические неврологические расстройства.
Затрудненность и медленное мочеиспускание чаще вызвано обструкцией уретры, но подобная патология может развиваться при уменьшении сократимости стенок мочевого пузыря.
Оценивается интенсивность и особенности половой жизни. У сексуально активных пациенток причиной резей при мочеиспускании считается уретрит или вульвовагинит, которые развиваются на фоне постоянной механической травматизации.
У женщин, страдающих сахарным диабетом, дизурию провоцирует урогенитальный кандидоз.
Важно
Во время беседы необходимо перечислить используемые препараты, биологически активные добавки, средства гигиены.
Есть данные, что дискомфорт при мочеиспускании возникает на фоне приема лекарств пенициллинового ряда, Циклофосфамида, Допамина, вагинальных спреев, спринцеваний, приема жемчужных ванн.
Гинекологический осмотр на кресле позволяет получить информацию о состоянии наружных половых органов, стенок влагалища, шейки матки, выходном отверстии мочеиспускательного канала.
Лабораторные исследования
Для установления причины резей при мочеиспускании необходимо сдать ряд анализов:
- общий анализ мочи и крови;
- пробу Нечипоренко;
- кровь на сахар;
- биохимию крови;
- посев мочи на флору и чувствительность к антибиотикам;
- цитологическое исследование мочи при подозрении на опухоль мочевого пузыря;
- исследование отделяемого влагалища и уретры;
- ПЦР-диагностику на инфекции, передающиеся половым путем.

Инструментальная диагностика
Инструментальное обследование включает следующее:
- УЗИ органов малого таза, почек, мочевого пузыря;
- уретроцистоскопию;
- обзорная и экскреторная урографию;
- микционная цистоуретрографию.
- КТ и МРТ;
- биопсию с гистологическим исследованием.
Важно
Схема обследования подбирается индивидуально, в зависимости от предполагаемой патологии.
Как лечить рези при мочеиспускании у женщин
Тактика терапии зависит от установленного диагноза, результатов обследования, выраженности клинической картины, сопутствующей патологии, возраста пациентки и ряда др. факторов.
Инфекционно воспалительные заболевания мочевого пузыря и уретры требуют проведения антибактериальной, противовоспалительной терапии с учетом чувствительности к антибиотику (при длительно существующем процессе или при отсутствии эффекта от предыдущего лечения).
Врач может порекомендовать курс инстилляций. В этом случае в мочевой пузырь с помощью специального эластического катетера вводят препараты с противовоспалительным, антибактериальным и обезболивающим действием.
В период ремиссии (в отсутствие симптомов) хорошо принимать отвары мочегонных трав:
- брусничный лист;
- полевой хвощ;
- толокнянка;
- семена укропа;
- почечный чай и пр.
Не менее важно придерживаться правильного питания. Из рациона необходимо исключить острое, кислое, соленое, копченое, алкоголь. Прием жидкости стоит увеличить до 1800 — 2000 мл в/сутки, если нет противопоказаний (например, повышенное артериальное давление).
Если причина резей при мочеиспускании нарушение обменных процессов с повышенным выпадением в осадок солей, можно использовать литолитические препараты. Универсальными травяными лекарствами, растворяющими соли и мелкие конкременты, считаются Цистон и Фитолизин
Дизурические расстройства на фоне гипоэстрогении подразумевают проведение заместительной гормональной терапии, если нет противопоказаний к приему эстрогенов (опухолевая патология, фибромиома, рак молочной железы).
Необходимо соблюдать некоторые гигиенические правила:
- не пользоваться ежедневными прокладками;
- регулярно принимать душ;
- использовать средства для интимной гигиены с нейтральной реакцией;
- носить нижнее белье из натуральных тканей;
- вовремя диагностировать и лечить кольпит;
- при приеме антибиотиков в профилактических целях принимать противогрибковые препараты;
- при первых признаках травматизации и раздражения выполнять орошения с отваром ромашки.
Если воспаление и раздражение возникают часто, хорошо помогают свечи с Метилурацилом трансвагинально в течение 5-7 дней.
Все процессы, подозрительные на инфекции венерической природы, должны быть своевременно выявлены и пролечены.
Важно
Лечение при ИППП проводится совместно с партнером. Во время лечения рекомендовано пользоваться презервативом.
Схема лечения определяется с учетом возбудителя. Основным компонентом назначается антибиотик, в качестве дополнительных средств применяют иммуномодуляторы, витамины, местную терапию.
Дивертикулы мочевого пузыря, стриктуры уретры, новообразования устраняются хирургическим путем.
Мишина Виктория, уролог, медицинский обозреватель
Вопрос-ответ
Что делать, если рези при мочеиспускании у женщин?
Любая боль, возникающая при мочеиспускании или локализующаяся в области половых органов, требует обращения к врачу. Первичную информацию о причине заболевания можно получить, сдав общий клинический анализ мочи. А также рост бактериальной культуры на питательных средах поможет подтвердить диагноз.
Что пить при болях при мочеиспускании?
№ 1 Канефрон. Германия. Бионика№ 2 Цистон. Индия№ 3 5-нок. Россия№ 4 Фитолизин. Польша№ 5 Монурал. Италия№ 6 Нитроксолин. Россия№ 7 Фурагин. Латвия
Когда хожу в туалет по-маленькому, в конце больно. ?
Почему женщине больно писать в конце мочеиспускания? Боль в конце мочеиспускания может быть признаком инфекционного заболевания мочеполовой системы, а также мочекаменной болезни. Для диагностики причины болей при мочеиспускании следует обратиться к гинекологу или урологу.
Почему режет в конце мочеиспускания?
Если у вас имеется боль в конце мочеиспускания, то, вероятно, проблемы имеются в мочевом пузыре. Если во конце мочеиспускания появляются болевые ощущения, резь, чувство жжения – необходимо заподозрить наличие воспаления уретры, или мочеиспускательного канала. Также эта боль может быть признаком цистита у женщин.
Советы
СОВЕТ №1
Важно не игнорировать симптомы. Если вы испытываете рези при мочеиспускании, обратитесь к врачу для диагностики. Это может быть признаком инфекции или другого заболевания, требующего лечения.
СОВЕТ №2
Поддерживайте водный баланс. Употребление достаточного количества жидкости помогает разбавить мочу и может снизить дискомфорт при мочеиспускании. Старайтесь пить не менее 1,5-2 литров воды в день.
СОВЕТ №3
Избегайте раздражающих продуктов. Некоторые продукты и напитки, такие как кофе, алкоголь, острые специи и цитрусовые, могут усугубить симптомы. Обратите внимание на свою диету и постарайтесь исключить эти продукты на время.
СОВЕТ №4
Регулярно проводите гигиенические процедуры. Соблюдение правил личной гигиены может помочь предотвратить инфекции и снизить риск возникновения резей. Используйте мягкие, нераздражающие средства для интимной гигиены.